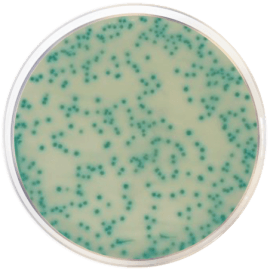
main product photo

Close
MRSA Agar CHROMOGENIC 500 grams/bottle
SKU
CDL/1423
Brand
CONDALAB
Pre-order (Deliver in 8 to 12 weeks)
MRSA Chromogenic Agar Base is a chromogenic, selective and differential medium for detection of methicillin resistant Staphylococcus aureus.
Methicillin resistant Staphylococcus aureus, MRSA, are of particular interest at an international level due to its virulence and resistance to multiple antibiotics. The antimicrobial resistance is a serious threat to public health as it is now regarded as a major hospital acquired disease worldwide. The important changes observed in the epidemiological and microbiological characteristics of the infections caused by Staphylococcus aureus are the reason for the increment and prevalence of methicilin-resitant Staphylococcus aureus nosocomial (associated to hopitalized patients) and the proliferation of methicilin-resistent Staphylococcus aureus acquired by the community. The MRSA continues being a serious problem in many healthcare centres; more than 50% of the Staphylococcus aureus obtained are from Intensive Care Units (ICU) and close to 40% are from hospital patients. Effective, rapid laboratory diagnosis and susceptibility testing is critical in treating, managing and preventing MRSA infections.
This chromogenic media has been designed and is adequate for the screening of Staphylococcus aureus resistant to methicillin. The alpha-glucosidase produced by Staphylococcus aureus cleaves the chromogenic substrate and gives a blue color to the Staphylococcus aureus colony. The cefoxitin inhibits the growth of Staphylococcus aureus sensitive to methicillin.
MRSA Chromogenic Agar Base is a chromogenic, selective and differential medium for detection of methicillin resistant Staphylococcus aureus.
Methicillin resistant Staphylococcus aureus, MRSA, are of particular interest at an international level due to its virulence and resistance to multiple antibiotics. The antimicrobial resistance is a serious threat to public health as it is now regarded as a major hospital acquired disease worldwide. The important changes observed in the epidemiological and microbiological characteristics of the infections caused by Staphylococcus aureus are the reason for the increment and prevalence of methicilin-resitant Staphylococcus aureus nosocomial (associated to hopitalized patients) and the proliferation of methicilin-resistent Staphylococcus aureus acquired by the community. The MRSA continues being a serious problem in many healthcare centres; more than 50% of the Staphylococcus aureus obtained are from Intensive Care Units (ICU) and close to 40% are from hospital patients. Effective, rapid laboratory diagnosis and susceptibility testing is critical in treating, managing and preventing MRSA infections.
This chromogenic media has been designed and is adequate for the screening of Staphylococcus aureus resistant to methicillin. The alpha-glucosidase produced by Staphylococcus aureus cleaves the chromogenic substrate and gives a blue color to the Staphylococcus aureus colony. The cefoxitin inhibits the growth of Staphylococcus aureus sensitive to methicillin.
| Brand | CONDALAB |
|---|
Write Your Own Review

Validate your login